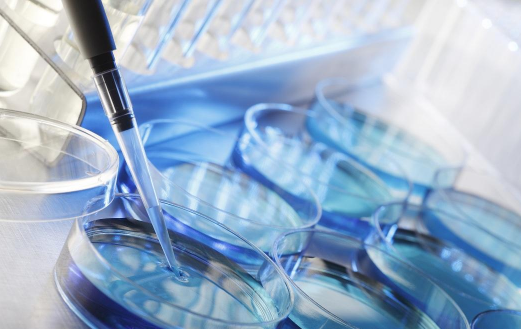

生态与捐赠卵
2020-08-25 16:25
带有供体卵的IVF可使您增加成功进行胚胎植入的机会,并进一步增加如果妇女无法自然怀孕或在ART程序中接受自己的劣质卵母细胞的情况。20多年来,NGC生殖与遗传学诊所的专家们已经成功地按照了准妈妈的意愿选择了供卵卵。
我们数据库中的卵子捐献者接受了所有必要的检查,从而证实了其高水平的健康状况,并因此具有获得高质量卵母细胞的能力。Cryobank NGC拥有来自300个不同捐赠者的1,500多个玻璃化卵。他们自己出生的健康孩子的存在是他们参加该计划的理想条件,但不是强制条件。为每位捐赠者准备一份问卷,包括有关其表型特征,健康状况(包括遗传护照)的信息,有关亲戚和孩子(如有)的信息,录音和手写信息。免费提供带有儿童捐赠者照片的问卷。可以通过联系诊所经理查看成人照片。
捐赠卵子进行IVF的适应症
1、由于对卵巢进行手术导致自身卵母细胞缺乏,更年期提前。
2、女人患有遗传病,无法生产自己的卵。
3、耐药卵巢综合征。
4、用ART方法治疗的许多失败尝试,包括获得自己的劣质卵。
5、卵巢储备减少。
6、卵巢缺失或发育异常,各种发育异常。
7、患者的生殖年龄晚,有发展出具有遗传异常的胚胎的风险。
IVF如何与供体卵一起工作?
可以使用新鲜和冷冻(玻璃化)卵母细胞进行供体的体外受精。
在第一种情况下,过程如下:
1、供体选择。在使用供体卵母细胞开始IVF之前,准妈妈研究其遗传材料目前可用的供体列表。
2、全面检查。根据俄罗斯联邦卫生部第107n号命令,捐赠者和接受者均应通过该命令。他们每个人都按照清单进行了必要的检查,并咨询主治生殖医生。
3、卵巢刺激(排卵刺激)。为了获得所需数量的卵母细胞,给供体注射促进所有肛门卵泡生长的含激素药物(在自然周期中只有一个成熟)。
4、月经周期同步。如果患者希望在不进行冷冻保存的情况下转移胚胎并进行非整倍性的植入前基因检测,则供体和受体的周期应提前同步。
5、滤泡穿刺。从卵泡收集卵母细胞是在静脉麻醉下在超声控制下通过阴道的穹for进行的。
6、受精。根据精子图参数或预选精子供体的材料,通过IVF或ICSI将得到的卵与受者丈夫的精子受精。
7、将胚胎转移到子宫腔中。使用IVF / ICSI成功受精的供体卵在特殊的平板培养箱中培养至胚泡期。使用特殊导管选择先导胚胎以转移到患者子宫腔中。该过程无痛且不需要麻醉。可以将已经达到胚泡期的其余胚胎冷冻(玻璃化)。
8、诊断妊娠。胚胎移植后12-14天,患者进行了第一次检查-hCG的血液检查。在超过65%的病例中,第一次手术后会发生妊娠。
如果使用玻璃化的供体卵进行体外受精,则在患者排卵当天或开始服用妊娠纹时进行除霜。此外,进行与使用“新鲜”卵母细胞时相同的步骤。
- 上一篇:NGC具有卵子捐赠者计划的优势
- 下一篇:没有了
